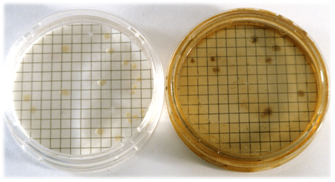

SPS (SULFITE POLIMIXIN SULFADIACIN) AGAR GRANULADO es el medio más empleado para recuento de clostridios sulfito-reductores en alimentos
Detección de clostridios sulfito‑reductores (AOAC,ICMSF)
COMPOSICIÓN
- Peptona de caseina 15,00 g
- Extracto de levadura 10,00 g
- Citrato de Hierro 0,50 g
- Sulfito sódico 0,50 g
- Polimixina‑B sulfato 0,01 g
- Sulfadiacina sódica 0,12 g
- Agar‑agar 13,90 g
(Fórmula por litro)
pH final: 7,0 ± 0,1
PREPARACIÓN
Disolver 40 g de medio en 1 litro de agua destilada. Calentar agitando hasta ebullición para su completa disolución.
Repartir en tubos o frascos. Autoclavar a 121 ºC durante 15 minutos, o mejor a 116 ºC durante 15-30 minutos. Enfriar rápidamente el medio en un baño de agua fría. El uso a [2] es más recomendable. Utilizar de inmediato a su preparación para evitar su oxigenación letal.
NOTA: Para mejorar el desarrollo de colonias negras de Clostridios, añada 1 vial del suplemento estéril VMT136 a cada 100-1000 ml de medio estéril, hervido para eliminar la oxigenación y una vez enfriado a unos 45-50 ºC.
PARA USO EXCLUSIVO EN LABORATORIO
MANTENER EL BOTE BIEN CERRADO EN LUGAR SECO, FRESCO Y OSCURO.
DESHIDRATADO CODIGO: DMT116
CONTROL DE CALIDAD DEL MEDIO
Realizado en nuestro laboratorio; es prudente repetirlo en su laboratorio siempre que varíen las condiciones (más de 3 meses sin usar, tras desinfectar laboratorio, tras conservar a alta Tª, cuando adquiere aspectos extraños aunque no haya llegado la fecha de caducidad teórica de la etiqueta,…)
DESHIDRATADO: Granulado, Beige
PREPARADO: Estéril, Crema-blanquecino
CONTROL DE CRECIMIENTO CUANTITATIVO 24 h a 37°C aproximadamente, en anaerobiosis:
- Clostridium sporogenes MKTA 11437, colonias gris-negras. Con respecto a PCA estandarizado*, recuento 240-347%, pero de forma más selectiva y diferencial.
- Clostridium perfringens MKTA 13124, colonias gris-negras. Con respecto a PCA estandarizado*, recuento 110-420%, pero de forma más selectiva y diferencial.
- Staphylococcus aureus MKTA 6538P, Inhibido.
- Escherichia coli MKTA 25922, Inhibido
* El que cumple con recuperación superior al 92-125% con respecto a cepas cuantitativas trazables a la cepa tipo. Incertidumbres detectadas entre todos los lotes a lo largo de un año (la mayoría de la incertidumbre se debe a la cepa y a la proporción de cepas acompañantes inoculadas, no al medio).
PRESENTACIÓN: TUBOS PREPARADOS (PARAFINADOS-9 ml O NO-18 ml), FRASCOS 50 ml A DOBLE CONCENTRACION PARAFINADOS, FRASCOS 100 y 250 ml, MEDIO DESHIDRATADO.
Selectivo para aislamiento/recuento de clostridios sulfito reductores. La reducción del sulfito ennegrece las colonias
SIEMBRA
En profundidad en placa con tubos y frascos fundidos, o en el propio tubo/frasco; incluso las membranas de MF, que se depositan entre 2 capas. Para esporas inocular tubos parafinados, calentando a unos 98 ºC, dejando enfriar a unos 75 ºC y añadiendo entonces 1 ml de muestra. Voltear sin agitar para mezclar con el medio y enfriar en posición vertical (para que la parafina solidifique en superficie en los tubos parafinados). Para buscar esporas en aguas, actuar igual pero con frascos parafinados a doble concentración y añadiendo 20‑50 ml de muestra. Incubar en anaerobiosis (los tubos, tubos parafinados y frascos parafinados no lo necesitan) a 35‑37 ºC aproximadamente, durante 24 horas.
INTERPRETACIÓN
Contar los puntos negros que aparezcan como clostridios sulfito‑reductores. Las colonias blancas son presuntivas si la anaerobiosis no es correcta.
El usuario final es el único responsable de la eliminación de los microorganismos según la legislación medioambiental vigente. Autoclavar antes de desechar a la basura.
Si desea más información sobre nuestros SPS (SULFITE POLIMIXIN SULFADIACIN) AGAR GRANULADO rellene nuestro formulario de contacto http://www.medioscultivo.com/contacto . O si lo prefiere póngase en contacto con nosotros a través de nuestro correo electrónico microkit@microkit.es o por teléfono en el nº 91-897 46 16